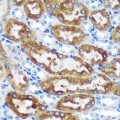
KO-Validated CHCHD2 Rabbit pAb (20 μl)

Your shopping cart is empty!
KD-Validated Antibodies
Reactivity: Human, Mouse, Rat Applications: WB, ELISA Host Species: Rabbit Isotype: IgG ..
Reactivity: Human, Mouse, Rat Applications: WB, IHC, IF/IC, IP, ELISA Host Species: Rabbit Is..
Reactivity: Human, Mouse Applications: WB, ELISA Host Species: Rabbit Isotype: IgG ..
Reactivity: Human, Mouse, Rat Applications: WB, IHC, ELISA Host Species: Rabbit Isotype: IgG&..
Reactivity: Human Applications: WB, ELISA Host Species: Rabbit Isotype: IgG ..
Reactivity: Human, Mouse, Rat Applications: WB, ELISA Host Species: Rabbit Isotype: IgG ..
Reactivity: Human Applications: WB, ELISA Host Species: Rabbit Isotype: IgG ..
Reactivity: Human, Mouse, Rat Applications: WB, ELISA Host Species: Rabbit Isotype: IgG ..
Reactivity: Human Applications: WB, ELISA Host Species: Rabbit Isotype: IgG ..
Reactivity: Human, Mouse, Rat Applications: WB, IHC, IF/IC, ELISA Host Species: Rabbit Isotyp..